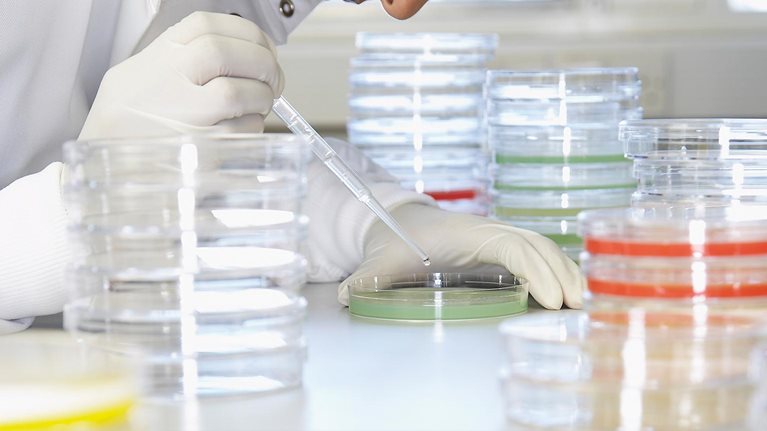
q15_web_roche-interview_103579108_1536x1536_Original

“Listen to your customer” is a business truism that approaches cliché, but the consequences of not adapting commercial models to market shifts can be severe. Ask anyone who experienced IBM’s near-death in the 1990s. Its customer base had largely shifted from centralized IT departments that bought mainframes to decentralized buyers of desktop computers, but IBM hadn’t responded (Fortune magazine labeled it a “dinosaur”). It took a CEO change and a decade of commercial transformation—major layoffs, massive reallocation of budgets across sales and marketing, and billions of dollars in acquisitions—to create new go-to-market capabilities such as a business consulting front end to the salesforce. IBM, of course, famously survived that transition and went on to thrive again in the era of e-business. Rivals who did not adapt, such as DEC, did not thrive.
This lesson is as germane in today’s hyperdigital world as it was in the 1990s. IBM’s commercial model had been the envy of the world for decades before the 1990s. IBM only changed it after understanding the extent of its customers’ changes.
Stay current on your favorite topics
In today’s pharmaceutical industry, many companies have strong, effective sales, marketing, and go-to-market activities, but a market shift is under way: the digital era is changing how millions of people think about and manage their health.
Many pharmaceutical companies know the market is shifting but still need to ask themselves hard questions about the scope, scale, and pace of their response in adapting their commercial models. If not, they may find themselves becoming the DEC of today’s change story.
The impact of digital: the digital citizen
Today, increasing numbers of patients and healthcare providers are “digital citizens,” people who don’t simply use digital technology but have fundamentally changed their expectations, worldviews and behaviors as a result of living in the digital age.
Digital citizens swim in a sea of information, are increasingly in control of what information they tune into, and actively choose what to tune out. They turn to digital information sources first for insights and have a high degree of trust in online reviews from peers. They are increasingly mobile-first and “untethered” in their digital interactions. Digital citizens are also social and media generators, sharing opinions, photos and other content with their digital community. They are advocates and influencers and expect others—individuals and companies—to contribute actively and authentically to their communities. They are equipped to discover the social contributions, purpose, and character of the companies with whom they do business. Finally, they have increasingly high expectations for the quality of experience when they interact with companies and individuals in person and online, shaped by their experiences across all sectors in their life, not just healthcare.
Physicians are digital citizens, too. Recent Google research into their digital habits shows how like consumers their behavior has become: 80 percent use their smartphone in their professional interactions with patients; 77 percent type keywords into the search box on their browser when they want to look up professional medical information, just as they do in their personal lives. And physicians are also social—about half share online videos with other doctors. SERMO, a company that’s created an app for doctors to search for medical information and case studies, and other physician communities continue to grow, providing a place to connect socially and to consult professionally.
In a world of digital citizens, the traditional pharma commercial model (i.e., a strong sales force combined with advertising and marketing collateral to communicate the product’s value proposition) looks increasingly outmoded. Digital citizens—both patient and physician—won’t passively receive promotional information from the product manufacturer. They’ll seek out information from peers. In a digital era, the patient-physician relationship around which the pharma commercial model was originally constructed is also different. Both patient and physician are active, informed, peer-enabled participants in managing health.
Would you like to learn more about our Life Sciences Practice?
Five imperatives for pharma commercial models
Pharma is fortunate to be able to learn from other sectors (e.g., retail, travel, financial services) about how companies can change their commercial models to serve Digital citizens effectively. These experiences suggests five imperatives for how pharma commercial models must change.
Focus on engagement, not just promotion. Engagement requires creating compelling stories and experiences fueled by strong content. While it’s been true for a while that “every company is a media company,” the sheer volume and variety of content has forced businesses to reevaluate their content strategies. Many companies are making major investments in content development, such as GE’s partnership with Imagine Entertainment to develop TV documentaries featuring GE science. Given the starting point in the pharma industry, virtually every company will need to expand its content supply chain considerably, build new relationships between content creators and regulatory groups, and create much faster microcycle approaches to creating, reviewing, revising, and publishing content.
Manage experience across touchpoints. The “CareFlow”—the series of interactions a patient or customer has with a brand—can be complex, requiring pharma companies to manage touchpoints in an integrated, coherent way. Marketers must identify what the digital citizen needs or will relate to at each moment when they’re making decisions, seeking information, or hoping to engage. Each offers an opportunity to connect with the person and deliver an experience or information tailored to that touchpoint. These touchpoints must also be orchestrated as a single system to have most impact. Pharma companies have special difficulty executing in this tailored but coordinated way because the range of customer touchpoints typically crosses different functional silos. Companies need to consider new structures, processes, and governance approaches—such as councils and cross-functional teams—to meet this challenge.
A useful reference is the hotel industry, which does this very well. One major chain, for example, created a single cross-functional team to travel the globe and find ways to make the customer experience better and more consistent across locations. The team meets with hotel licensees, educates them about the company’s customer-engagement approach, and inspects—and, helps improve, if necessary—touchpoints that don’t deliver the target experience.
Expand the portfolio of touchpoints. Pharma companies should engage with digital citizens throughout their daily lives, not just at a point of purchase or in the doctor’s office. Pharma commercial models often focus primarily on those moments that are closest to generating the prescriptions, but building trust is based on a deeper set of interactions that provide value to digital citizens over a longer time frame. In practice, this means creating new ways to connect with customers, such as expanding the set of external partnerships and sponsorships pharma companies engage in as part of their commercial models.
Strengthen digital commercial capabilities. Three capabilities are key additions to existing commercial models: analytics, experience design, and test-and-learn approaches to innovation.
- In analytics, the ability to integrate data from various sources—such as historical claims and co-payment data, customer-support and call-center experiences, sales-rep learning, and social- media monitoring—into a coherent view of customer behavior is essential. It enables the creation of predictive, algorithm-driven analytic models to help speed the translation of insights into specific, business-actionable recommendations.
- Designing great customer experiences is growing increasingly important in pharma. We know that digital citizens’ expectations for the quality of experience are set by all their interactions with brands outside of pharma, where many other sectors are far ahead. Most pharma companies need to strengthen their experience-design capabilities to deliver both better interactions at particular touchpoints and an integrated and coherent experience across all touchpoints.
- The test-and-learn approach to commercial innovation—e.g.,, rapid prototyping and A/B testing of value propositions and messaging—in pharma commercial models is generally far behind other leading industries. Pharma companies will need to build the capabilities to track, measure, and act on results in order to continuously improve their commercial innovation and execution.
Reallocate investment across the commercial model. Finally, pharma companies can save large amounts of money by shifting their legacy go-to-market operations to new, digital channels. Many companies are already turning to lower-cost channels, substituting telesales for face-to-face reps and customer web self-service for call-center personnel. Many are also reducing spending by using insights and digital capabilities to more precisely target sales and marketing activities.
Despite the opportunities, overcoming the inertia embedded in existing commercial models requires leadership commitment and dedication to testing new channels, measuring results, and adapting commercial activities based on the new learning.
To judge if we are changing our commercial models enough for the digital era, we should focus not on the recent performance of our commercial model or our ability to accommodate incremental digital tactics within it, but on how well we are connecting with today’s patients and physicians. There are only going to be more digital citizens, with incrementally greater potential to profoundly reshape pharma markets. The survival of today’s pharma companies depends on how well—and how quickly—they embrace the five imperatives and evolve their commercial models.